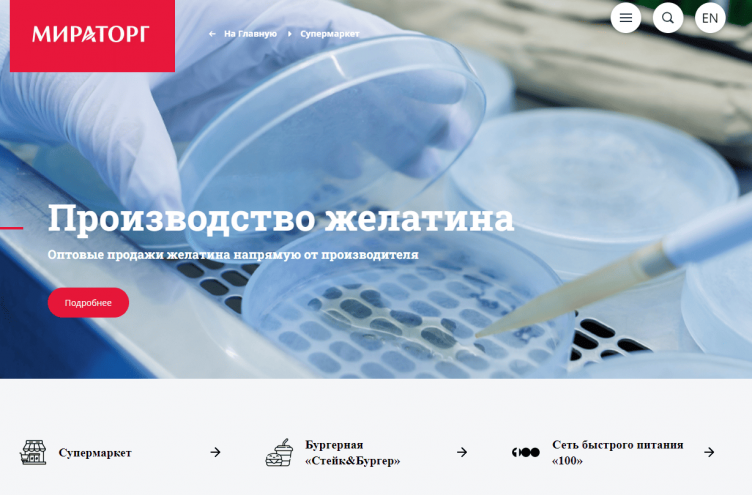
Интернет-магазин Мираторг

Нажмите на кнопку «Открыть промокод» или «Открыть акцию».


Скопируйте секретный промокод и перейдите на сайт магазина или сервиса.

При оформлении заказа вставьте код и получите дисконт.
Изучите бесплатные купоны, внимательно прочтите условия и проверьте срок действия выбранного предложения. Кликните «Открыть код», если это предусмотрено условиями акции, скопируйте кодовое слово и переходите в интернет-магазин Мираторг.
Система предложит выбрать город и адрес, а также дату и время доставки. Исходя из этих данных будет сформирован каталог – выберите здесь все интересующие позиции с телятиной, бараниной, говядиной, свининой, крольчатиной, курицей и добавьте их в корзину. Обратите внимание на баннеры – время от времени Miratorg дарит бонус новым клиентам.
Система предложит выбрать город и адрес, а также дату и время доставки. Исходя из этих данных будет сформирован каталог – выберите здесь все интересующие позиции с телятиной, бараниной, говядиной, свининой, крольчатиной, курицей и добавьте их в корзину. Обратите внимание на баннеры – время от времени Miratorg дарит бонус новым клиентам.
 Закончив покупки, перейдите в нее для оформления заказа. Справа от списка найдите строку «Промокод», вставьте сюда эксклюзивный код на скидку, скопированный ранее, а затем кликните «Ввести промокод». Убедитесь, что сумма к оплате снизилась, – если этого не произошло, проверьте условия оферты, попробуйте вписать код вручную или используйте другой вариант экономии из нашего списка.
Закончив покупки, перейдите в нее для оформления заказа. Справа от списка найдите строку «Промокод», вставьте сюда эксклюзивный код на скидку, скопированный ранее, а затем кликните «Ввести промокод». Убедитесь, что сумма к оплате снизилась, – если этого не произошло, проверьте условия оферты, попробуйте вписать код вручную или используйте другой вариант экономии из нашего списка.
 При сумме покупки от 300 рублей Мираторг Супермаркет дарит карту лояльности, которую нужно привязать к учетной записи. Участники бонусной программы получают по 1 баллу за каждый 100 рублей, а также в приложении, в день рождения и в честь других событий.
При сумме покупки от 300 рублей Мираторг Супермаркет дарит карту лояльности, которую нужно привязать к учетной записи. Участники бонусной программы получают по 1 баллу за каждый 100 рублей, а также в приложении, в день рождения и в честь других событий.  Баллами можно компенсировать до 100% суммы последующих чеков.
Баллами можно компенсировать до 100% суммы последующих чеков.
Выгода 15% на все товары при покупке от 800 рублей без учета стоимости доставки. Предложение не пересекается с другими акциями.
Скидка 300 рублей действует для нового пользователя и только на первый заказ при покупке любых продуктов от 2000 рублей.
Большой выбор готовой мясной продукции. покупайте шашлык с выгодой до 20%. Ограничений по минимальной сумме чека нет.
Колбасная и мясная детская продукция из линейки Дети на ракете по выгодным ценам, скидка 10% при оптовом заказе продуктов.
Получите дополнительную скидку после активации промокода. Специальное предложение действует на все продукты и товары из каталога 2022 года.
Торговая сеть аграрно-производственного предприятия Miratorg реализует продукцию бренда с бесплатной доставкой по крупным городам России. Интернет-магазин предлагает изучить новые рецепты, воспользоваться акциями, поучаствовать в розыгрышах ценных призов и получить дополнительную выгоду при подключении бонусной программы. Активируйте промокод Мираторг, чтобы приобрести качественную мясную продукцию со скидкой. В каталоге представлены мраморная говядина сухого вызревания, бургеры, фарш, котлеты, стейки собственного приготовления, а также морепродукты, рыба, молоко, бакалея.